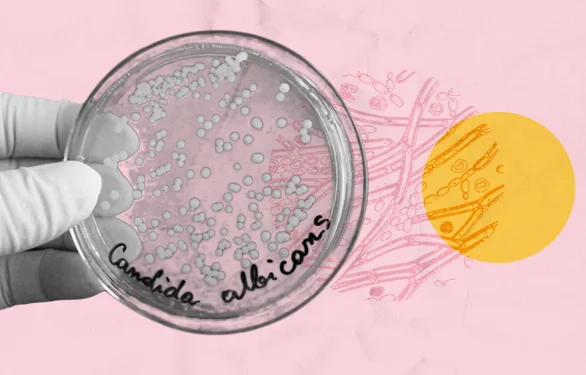
чашка петри

Молочница у женщин

Есть болезни, кричащие о проблемах со здоровьем, доставляя человеку всяческие неудобства. Болезненные ощущения и раздражение словно сигнализация оповещают о сбоях в работе тела. И если головную или зубную боль можно вылечить прямым воздействием на очаг боли, то заболевания внутренних органов требуют комплексного подхода.
ЧТО ТАКОЕ МОЛОЧНИЦА
Давайте поговорим о молочнице. Что мы о ней знаем?
Молочница или вагинальный кандидоз представляет собой расстройство микрофлоры слизистой оболочки влагалища. В норме слизистая влагалища имеет влажную среду, в которой обитают грибы рода Candida. Их количество сохраняется в пределах допустимого так, что естественная флора не нарушается. У здоровой женщины организм сам поддерживает баланс этих грибов.
По статистике, молочнице подвержены 45 % женщин фертильного возраста – с 18 до 45 лет. Активная жизнь не всегда сопровождается здоровым образом жизни, и именно в это время женщина уязвима перед заболеваниями. Развитию грибковых инфекций прежде всего способствуют плохая гигиена, неправильное питание, наличие вредных привычек и неразумное применение контрацептивов. От этих воздействий, здоровая среда обитания грибков Candida окисляется, что является подспорьем для их размножения. Возникает молочница.
ГДЕ ЕЩЕ МОЖЕТ ПОЯВЛЯТЬСЯ МОЛОЧНИЦ
Поскольку дрожжи естественным образом живут в слизистой и тканях, возможны и другие типы кандидоза в зависимости от локализации:
- кожный – появляется на коже в виде выпуклого красного пятна с небольшими зудящими бугорками. Образуется в складках кожи, например, в подмышечных впадинах, под грудью и возле ягодиц или в паху в основном из-за опрелостей;
- оральный – вызывает белые язвы в слизистой: в полости рта, горле, пищеводе, кишечнике или языке. Сопровождается ощущением хлопка во рту, потерей вкуса, болью во время еды, трещинами и покраснениями в уголках и полости рта. При поражении пищевода появляется боль и затруднения при глотании. Редко встречается у здоровых взрослых. В группе риска люди, которые носят зубные протезы, имеют диабет, рак, ВИЧ, СПИД или астму, курят;
- гранулема – тяжелая инфекция, поражающая кожу головы, губ и ногтей. Этот синдром характеризуется появлением в раннем детстве обширного поверхностного кандидоза, который протекает много лет. Имеет тенденцию к рецидивам после лечения, часто встречается у мужчин;
- инвазивный – серьезная инфекция, которая распространяется по всему телу через кровь. Возникает, когда грибок попадает в кровоток или внутренние органы в ходе медицинских процедур. Например, когда центральный венозный катетер вставлен и оставлен на месте надолго, во время операции или когда иммунная система ослаблена. Медицинские работники также могут быть переносчиками грибков.
ПРИЧИНЫ МОЛОЧНИЦЫ
По мере того, как девочки взрослеют и достигают половой зрелости, гормональные изменения могут сделать их более склонными к дрожжевым инфекциям. Иногда девочки заражаются молочницей прямо перед менструацией. Причины, вызывающие молочницу, могут быть самыми разными: от образа жизни до наличия серьезной болезни. Что интересно, по ее появлению можно определить принимает ли человек лекарства или нет. К примеру, антибиотические препараты убивают все бактерии без разбора, включая те микроорганизмы, которые препятствуют размножению грибов Candida. То же касается и приема гормональных препаратов. Это означает, что длительный прием лекарственных средств без контроля может влиять на развитие кандидоза.
Выделяют следующие факторы возникновения молочницы:
- механические – нарушение личной гигиены, ношение синтетического белья, повреждение тканей влагалища, применение дезодорированных средств умывания;
- физиологические – беременность, менструация, прием противозачаточных препаратов с высокими дозами эстрогена, гормональная терапия эстрогенами;
- психологические – затяжной стресс, депрессия, анорексия, вредные привычки;
- сопутствующие болезни – онкологические заболевания, болезни щитовидки, цирроз печени, авитаминоз, аллергические болезни;
- прием лекарств – антибиотики, лечащие инфекции во всем организме, убивают полезные бактерии во влагалище. Хорошие бактерии контролируют дрожжи. Без хороших бактерий баланс смещается, что приводит к дрожжевой инфекции;
- иммунные – течение и лечение таких заболеваний, как ВИЧ, СПИД и рак подавляют сопротивление иммунитета воспалениям.

Молочница, как правило, не передаётся половым путём, но если заболевание выявлено у одного из партнеров, половой контакт лучше исключить до полного исчезновения признаков.
ПАТОГЕНЕЗ ВАГИНАЛЬНОГО КАНДИДОЗА
Гриб Candida albicans является самым патогенным из рода Candida, то есть способным вызывать расстройства естественной среды, болезни. В зависимости от условий существования, гриб размножается и меняет структуру поверхности, на которой обитает. Этот вид гриба способен проявлять свойства, схожие с нормальными клетками человека. Это значит, что организм может не заметить возбудитель, и восприимчивость на гриб окажется сильной. Тогда в борьбу с паразитарными воспалениями можно подключить активную добавку Antiparazit. Он оказывает противовоспалительное, иммуновосстанавливающее и антидепрессивное воздействие.
В развитии кандидоза большое значение имеет повреждение слизистой. Ее барьерные функции могут нарушаться как от внешнего воздействия (трения, ранения, раздражения), так и от ослабления внутренних ресурсов (иммунодефицита, болезни). При нарушениях целостности слизистой пропивается курс активаторов, способствующих регенерации и укреплению оболочек и тканей. Из рекомендуемых средств – Regen.
Внешние факторы размножения грибков – это химические и механические повреждения, нарушающие целостность кожных покровов и слизистых оболочек. Большую роль в этом играют образ жизни человека: активность, уход за собой, опрятность, питание, род деятельности (стрессовый фактор), вредные привычки.
К внутренним факторам относятся:
- иммунная недостаточность;
- нарушения обмена веществ: содержания белков, жиров, углеводов, витаминов, минералов в организме;
- сахарный диабет, аменорея;
- железодефицитные состояния;
- затяжные заболевания желудочно-кишечного тракта, в частности, пониженная кислотность желудочного сока;
- заболевания инфекционной и неинфекционной природы;
- заболевания женских половых органов;
ФОРМЫ ВАГИНАЛЬНОГО КАНДИДОЗА
В зависимости от того, как протекает болезнь, различают неосложненный, острый и хронический вагинальный кандидоз.
Болезнь считается неосложненной, если она обнаружена впервые или беспокоит не чаще четырёх раз в год средними проявлениями симптомов без сопутствующих болезней.
Кандидоз диагностируется в острой форме, когда на коже половых органов появляются волдыри с прозрачным или мутным наполнением, а во влагалище образуются трещины. Из-за этих признаков ухудшается психоэмоциональное состояние женщины, снижается активность и развиваются нервные расстройства. Такая форма кандидоза часто возникает при пониженном иммунитете.
Молочница считается хронической, если болезнь непрерывно протекает более 2-х месяцев, с интенсивными признаками в периоды обострений.
СИМПТОМЫ ВАГИНАЛЬНОГО КАНДИДОЗА
В ответ на инфекцию грибами Candida организм начинает подавать следующие сигналы:
- густые белые выделения, похожие на творог, кисломолочный запах выделений;
- зуд, раздражение, отек и краснота слизистых оболочек;
- усиление зуда во время сна, после водных процедур и полового акта;
- болезненность при половом акте;
- жжение при мочеиспускании;
Если симптомы не ограничиваются перечисленными, а сопровождаются трещинами кожи и слизистых оболочек, образованием пузырей и иными обострениями, это говорит о переходе молочницы в более тяжелые формы.
Специалисты рекомендуют
ОСЛОЖНЕНИЯ МОЛОЧНИЦЫ У ЖЕНЩИН
Когда молочница проявляется остро и распространяется в другие области женской половой структуры, начинаются осложнения. От степени тяжести протекания, молочница может переходить в опасные болезни:
- стеноз – воспаляются стенки влагалища и становятся менее эластичными, просвет влагалища сужается, возникают болевые ощущения при половом акте;
- сальпингит, оофорит – воспаляются маточные трубы, яичники. Проявлены боли в области придатков, повышенная температура тела, общая слабость и тошнота. Возможен риск осложнения в виде инфицирования органов малого таза, бесплодия, внематочной беременности;
- уретрит – воспаляется слизистая мочевыводящего канала. Характерны болезненное мочеиспускание, чувство жжения в области мочеиспускательного канала, кровяные или гнойные выделения с мочой, болезненность от касания с бельём, прилипание краев уретры, покраснение в зоне мочеиспускательного канала;
- цистит– воспаляется мочевой пузырь. При цистите к симптомам уретрита добавляются учащенные позывы "по-маленькому", мочеиспускание по капле, ощущение рези в конце мочеиспускания, боли внизу живота, мутность мочи;
Молочница очень опасна в беременность, поскольку появляется риск осложнений и заражения плода на ранних стадиях.
ДИАГНОСТИКА РАЗВИТИЯ МОЛОЧНИЦЫ
Многие женщины занимаются лечением симптомов в домашних условиях. Бытовое назначение медицинских препаратов сложило о молочнице впечатление, как о заболевании, не требующем точной диагностики. Некоторые сайты даже рекомендуют самолечение как эффективный метод терапии.
По данным одного опроса, 73% женщин с хроническими вагинальными симптомами лечились самостоятельно с помощью безрецептурных препаратов, а 42% использовали альтернативные средства. Все пациентки думали, что у них вагинальный кандидоз, но при обследовании в специализированной клинике он был диагностирован только у 28%. Данные также показали, что больные, однажды перенесшие молочницу, могли поставить точный диагноз в 82% случаев только на основании симптомов. И только 11% смогли распознать классический сценарий дрожжевой инфекции впервые.
Действительно, молочницу довольно легко диагностировать по внешним характеристикам. Однако это не значит, что нужно заниматься самолечением. Или, например, быть уверенным в том, что имеющийся сахарный диабет стал причиной молочницы. Диагностика молочницы начинается в клинике в кресле гинеколога и заканчивается диагностикой посева. В ходе осмотра врач определяет форму болезни и назначает лабораторные тесты. При сборе анамнеза важно понимать, что симптомы, связанные с молочницей, включают широкий спектр проявлений, которые выходят далеко за рамки изменений вагинальных выделений. Тщательный сбор анамнеза должен включать вопросы о характере, количестве и цвете выделений, а также о покраснении, зуде, жжении, болезненности при мочеиспускании и половом акте.
Если грибок поразил мочевыводящие пути, понадобится консультация уролога. Уролог назначает и проводит дополнительные диагностические мероприятия: УЗИ мочевого пузыря, исследование мазка из уретры, анализ мочи. Одновременно с этим, делается отбор крови на сахар. При уровне сахара выше нормы рекомендована консультация эндокринолога.
Критерии диагностики молочницы включают:
- типичные творожистые выделения из влагалища;
- пониженный рН влагалища < 4,5;
- почкующиеся дрожжи, псевдогифы или мицелии, видимые на влажном препарате, особенно с гидроксидом калия.
Если симптомы указывают на молочницу, но признаки (в том числе раздражение вульвы) отсутствуют, а микроскопия не обнаруживает элементов грибков, проводят посев. Больным с частыми рецидивами требуется посев для подтверждения диагноза и исключения кандидозного основания.
ЛЕЧЕНИЕ ВАГИНАЛЬНОГО КАНДИДОЗА
Лечение молочницы начинается с диагностики. Если жалобы пациентки и объективный характер болезни подтверждаются тестами на повышенное количество Candida в организме, врач назначает лечение.
В борьбе с легкой стадией кандидоза помогут противомикробные препараты местного применения – вагинальные свечи, таблетки, кремы, и для приема внутрь – таблетки, капсулы. В зависимости от дозы, препараты направлены либо на замедление роста грибков, либо на их полное уничтожение.
Во время лечения важно придерживаться правильного ухода за интимными зонами. Ежедневно менять нижнее белье и полотенца, гигиенические процедуры проводить без использования косметических средств. Рекомендуется отказаться от ношения синтетических трусов и капроновых колготок, не пользоваться чужими предметами гигиены. В комплексе с медикаментами эти простые правила ухода за собой довольно быстро избавят от кандидоза.
В случае тяжелой формы кандидоза, берутся во внимание результаты эндокринологических и урологических обследований. Назначаются препараты для укрепления иммунитета и роста полезных микроорганизмов в пораженной слизистой. Иными словами, в подпорченную молочницей среду искусственно запускаются помощники извне – новые микроорганизмы и питательные вещества, восстанавливающие баланс микрофлоры.
Молочница может не исчезнуть раз и навсегда. Пройдя курс лечения, необходимо повторно обратиться к врачу, чтобы удостовериться, что все в порядке.
НЕМНОГО О ГРИБАХ
От 85% до 90% штаммов дрожжей, выделенных из влагалища, принадлежат к виду Candida albicans. Другой род дрожжей насчитывает до 15% случаев. Из них glabrata является второй основной причиной кандидоза – до 10% случаев, в то время как krusei, parapsilosis и tropicalis составляют большинство остальных. Вагинальные симптомы, возникающие в результате инфекции этими видами, часто описываются как более легкие, чем те, которые вызваны Candida albicans. Однако врожденная сопротивляемость к препаратам класса азолов, а также приобретенные механизмы резистентности могут усложнить их лечение. Иногда требуются длительные противогрибковые схемы или альтернативные подходы к лечению. Например, вагинальные суппозитории с борной кислотой.
ИСКЛЮЧЕНИЕ ДРУГИХ ВАГИНАЛЬНЫХ ЗАБОЛЕВАНИЙ
Некоторые заболевания могут развиваться как молочница. Обратитесь к врачу, если:
- за короткое время у вас было несколько эпизодов молочницы;
- недавно совершали половой акт без презерватива с новым партнером;
- есть боль в области таза или аномальное кровотечение;
- вы занимались самолечением молочницы, но симптомы не исчезли.
ДИЕТА ПРИ МОЛОЧНИЦЕ
Диета уже давно зарекомендовала себя как действенный способ профилактики и лечения любого заболевания. Список продуктов, которые лучше исключить при склонности к молочнице, похож на диету диабетиков и людей, страдающих от болезней органов пищеварения. А среди продуктов, рекомендуемых к употреблению, все те же отварная рыба и злаки.
Нельзя:
- сладости, сахар, мед, сухофрукты;
- бобовые, орехи;
- выпечка, сдоба;
- острые приправы, соусы, кетчуп, майонез;
- копчености, соленья, маринады, уксус;
- животные жиры;
- квас, алкоголь;
- сыры, полуфабрикаты, фастфуд;

Нужно:
- кисломолочные продукты;
- овощи в любом виде, кроме соленых и маринованных;
- зелень;
- отварное мясо птицы и рыбы;
- цельнозерновой хлеб, хлеб с отрубями;
- растительные масла;
- кисло-сладкие ягоды и фрукты;
- злаковые каши;
При соблюдении такой диеты симптомы болезни уходят быстрее, лечение проходит эффективнее.
ПРОФИЛАКТИКА ЗАБОЛЕВАНИЯ
Грибок Candida постоянно присутствует в организме, а его размножение сдерживается собственными силами флоры. Это значит, что вероятность развития кандидоза полностью зависит от человека. От того, как он будет обращаться со своим телом.
Именно поэтому даже после прохождения полного лечения важно выполнять простые рекомендации в последующем:

- соблюдать интимную гигиену (частые и обильные подмывания без хим средств);
- не носить белье из искусственных материалов (лучше белье из хлопка);
- не носить плотные синтетические колготки подолгу;
- избегать переохлаждений органов малого таза;
- пользоваться только личными средствами ухода (бритва, полотенце);
- следить за питанием, обогащать рацион;
- вести активный образ жизни (физическая культура);
- обеспечить себе здоровый сон, меньше нервничать;
- воздержаться от безрецептурного использования местных препаратов с азолами, поскольку это может вызывать устойчивость болезни к противогрибковым препаратам;
В профилактических целях специалисты нередко советуют заменить привычные ритуалы кофе и чаепития отварами из натуральных трав, пропить курс витаминов и биологически активных добавок. Antiparazit 2 устраняет инфекционные процессы на коже и слизистых, выводит шлаки и токсины, предупреждает появление кожных заболеваний. Необходимая доза целебных веществ содержится в готовом виде
Специалисты рекомендуют

Подписывайтесь
на нашу рассылку

При подписке вы принимаете условия
Политики конфиденциальности и Обработки персональных данных
Укажите свои контактные данныи мы свяжемся с вами в ближайшее время.
Ваши данные успешно отправлены
Новый адрес добавлен.
Ваш адрес обновлен.
Как увеличить скидку?
После 1 покупки - постоянная скидка 5%
После 2 покупки - постоянная скидка 7%
После 3 покупки - постоянная скидка 10%
После 4 покупки - постоянная скидка 15%
ПОДАРОК к 5 заказу - Натуральный коллаген 1 кг
Учитываются заказы на сумму от 790 000 сум*
За что начисляются бонусы?
Бонусы за приглашенных друзей
1 друг = 150 000 бонусов








